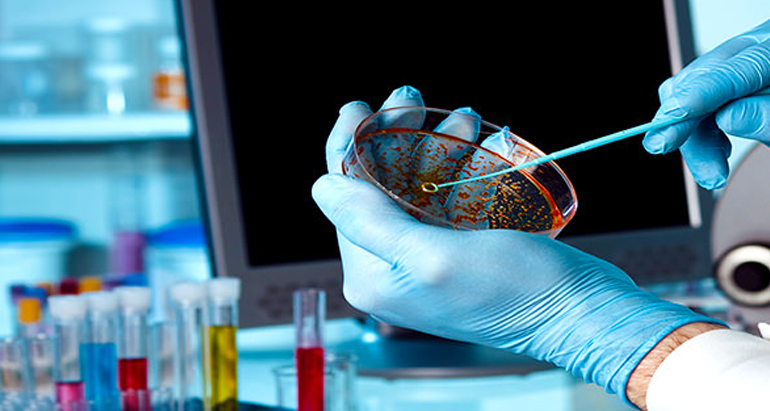
image

Department of Micro Biology
Department of Micro Biology
The B.Sc. Microbiology programme at Sathya Saai Arts and Science College for Women, affiliated to Annamalai University, provides a solid foundation in the science of microorganisms and their interactions with humans, animals, plants, and the environment. This undergraduate programme is designed to equip students with both theoretical knowledge and practical skills in areas such as medical, environmental, industrial, and food microbiology.
The department fosters a scientific mindset and cultivates curiosity about the microscopic world. Students are trained in handling microscopes, culture techniques, sterilization methods, and biochemical testing. With hands-on laboratory sessions and guided project work, the course aims to develop both academic excellence and research aptitude.
The department regularly conducts seminars, exhibitions, and awareness drives on public health, hygiene, and environmental microbiology. Through interactive learning and real-world application, the programme ensures students become knowledgeable and responsible citizens in the field of life sciences.
The B.Sc. Microbiology programme is structured under the Choice Based Credit System (CBCS) and spans six semesters. The core subjects include General Microbiology, Cell Biology, Immunology, Medical Microbiology, Industrial Microbiology, Environmental Microbiology, Molecular Biology, Genetics and Biotechnology. Emphasis is laid on both conceptual understanding and practical experimentation.
The curriculum also includes Allied Chemistry and Biochemistry to support interdisciplinary learning. Students undergo practical training in culture techniques, microbial staining, antibiotic sensitivity testing, and biochemical assays. Courses such as Environmental Studies, Soft Skills, and Bioethics are integrated to promote overall development.
Mini projects, case studies, field visits, and laboratory internships are part of the academic plan. Syllabus updates by Annamalai University ensure students stay current with scientific advancements. The programme also encourages students to present papers and participate in academic forums to improve their scientific communication.
Graduates of B.Sc. Microbiology can pursue careers in medical laboratories, pharmaceutical industries, research institutes, food safety organizations, agriculture, and environmental testing labs. Roles such as microbiologist, lab technician, quality control analyst, research assistant, and biotech associate are commonly available.
The degree also serves as a strong base for higher studies like M.Sc. Microbiology, M.Sc. Biotechnology, M.Sc. Medical Lab Technology, M.Phil., Ph.D. or professional diplomas in clinical microbiology and public health. Opportunities are also open in government and private healthcare sectors through competitive exams.
This programme is ideal for students who wish to contribute to the fields of health, agriculture, and environmental sustainability. The department is committed to nurturing skilled women scientists with strong ethics and a passion for scientific discovery.
Duration : 3 Years
Total Semester : 6
Medium of Teaching : English
Syllabus : Download

